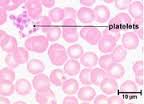
prp

Regenerative Medicine: PRP Platelet Rich Plasma and Stem Cell Therapy
What is REGENERATIVE MEDICINE?
Regenerative medicine utilizes the body's own cells to heal and regenerate damaged tissues. This therapy can be used for acute (sudden) or chronic conditions.
Therapy can utilize either Platelet Rich Plasma or Bone Marrow Aspirate Concentrate also known as "Stem Cells". At this time we are primarily utilizing Platelet Rich Plasma (PRP) as it is the easier to obtain and concentrate and works very well in the most commonly treated diseases.
What can regenerative medicine be used for?
-
Osteoarthritis including hip dysplasia
-
Knee injuries including partial cruciate ligament tears
-
Tendon, ligament and muscle injuries
-
Wound repair including burns and slow-healing wounds
-
Certain spinal conditons

What is Platelet Rich Plasma?
Platelet Rich Plasma (PRP) is a highly concentrated blood sample that contains isolated cells called platelets and some of the blood liquid called plasma. When used as therapy, PRP can regenerate and heal tissues by:
-
Recruiting other healing cells to come into an injured or diseased area to clean the area and remove other damaged cells
-
Releasing proteins called "Growth Factors" that stimulate tissue regeneration
What is involved with PRP Therapy?
First, having and accurate diagnosis is critical to determining if your pet is a good candidate for PRP therapy. If that is determined, we draw blood from your pet, process it with the special equipment we have, and inject it into the damaged or diseased area. This is often done with sedation during a scheduled visit time. From the time the sample is drawn until it is injected into your pet is about half and hour. In some cases more than 1 area can be done in a visit.
What results can be expected from PRP therapy?
After the procedure there may be some pain, swelling and discomfort. Certain pain medications and ice or hot packs also are avoided for a few weeks. Improvement is usually noted in a few weeks with some animals needing a second treatment in a month or two, but many patients with chronic conditions having improvement for 6-12 months. (such as dogs with hip dysplasia caused arthritis)
What are Stem Cells?
Stem cells have the ability to differentiate into any type of other cell in the body. They also activate other surrounding stems cells to assist in the work of repair and healing.
Stem cell therapy is similar but a sample of bone marrow must be obtained and concentrated before it is injected into the diseased area. We feel this therapy holds great promise for patients with spinal cord diseases. Due to the ease and effectiveness of PRP, for most other disease issues that is the prefered therapy.
If you feel your pet would benefit from this type of therapy please feel free to make an appointment for a consultation. Please also remember that therapy is performed only after a diagnosis has been made. We look forward to helping you and your pet!